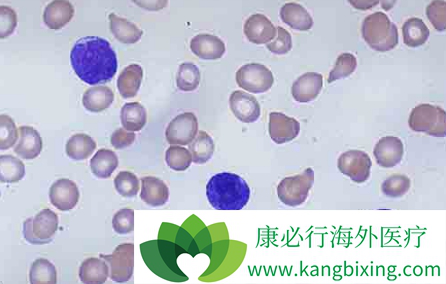

慢粒白血病(CML)的四期随机临床试验(IRIS)对伊马替尼(Imatinib)治疗过程中的副作用及分子学反应进行了定期记录。研究纳入了1503例接受伊马替尼治疗的患者,其中1379例为伊马替尼单药治疗。中位随访7.1年,仍有 951 例(64%)的患者继续接受伊马替尼治疗。10 年无进展生存率及总生存率分别为 82% 及 84%。
该研究主要通过分子学反应及药物不良反应(ADR)来评估伊马替尼治疗的有效性及安全性。研究同样对高剂量与标准剂量伊马替尼、伊马替尼联合干扰素与伊马替尼单药治疗的疗效及 ADR 进行了比较。8 年 ADR 的发生率为 76%,3-4 级不良反应为 22%,非血液学及血液学不良反应分别为 73% 及 28%。在伊马替尼口服同时加用干扰素治疗时,更易出现 ADR。多数患者较早出现 ADR,随着治疗进行发生率逐渐减低,未发现新的晚期毒副作用。
不管是伊马替尼(Imatinib) 400mg qd 及 800mg qd 口服,单药抑或联合干扰素治疗,副作用均较为常见,但均为轻度且是可以控制的。较高的深层次分子学缓解率提示多数患者均符合伊马替尼停药试验要求。因此 10 多年后,对于多数 CML 患者,伊马替尼仍是一种较好的起始治疗选择。
详情请访问 格列卫 http://glw.kangbixing.com/

添加康必行顾问,想问就问












